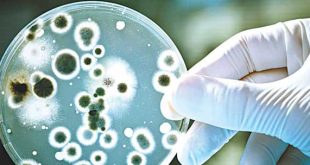

Ένα δύσκολο Σαββατοκύριακο πέρασαν τα Διαγνωστικά Κέντρα, καθώς έλαβαν από τον ΕΟΠΥΥ το ποσοστό αυτόματης περικοπής υπέρβασης των δαπανών Α’ εξαμήνου 2018. «Το καταστροφικό μέτρο του claw back προσδιορίζεται ακόμη και για το πιο μικρό Μικροβιολογικό εργαστήριο στο 19%, για το πιο μικρό Ακτινολογικό εργαστήριο το οποίο διενεργεί εκτός από απλές ακτινογραφίες και εξετάσεις μαστογραφίας, εξετάσεις μέτρησης οστικής πυκνότητας και …
Περισσότερα »Yearly Archives: 2019
Σε επαγρύπνηση καλεί τους καταναλωτές ο ΕΟΦ για προϊόν που κυκλοφορεί σε μορφή ροφήματος
Ο ΕΟΦ ανακοίνωσε ότι, «σύμφωνα με ενημέρωση των αρμόδιων αρχών των ΗΠΑ, το προϊόν Kopi Jantan Tradisional Nature Herbs Coffee, που κυκλοφορεί με την μορφή στιγμιαίου ροφήματος σε φακελάκια, περιέχει τις φαρμακευτικές ουσίες σιλδεναφίλη και ταδαλαφίλη, χωρίς αυτές να δηλώνονται στην επισήμανση του. Το προϊόν είναι πιθανόν να διακινείται στην Ελλάδα μέσω διαδικτύου. Συνεπώς, κατά τη χρήση του ανωτέρω προϊόντος, ελλοχεύει σοβαρός κίνδυνος για την …
Περισσότερα »Ε.Π.Ε.: Εκδήλωση για τη διακοπή καπνίσματος στα… άκαπνα Τρίκαλα
Η Ελληνική Πνευμονολογική Εταιρεία (Ε.Π.Ε), στο πλαίσιο των δράσεων που υλοποιεί με αφορμή τον φετινό εορτασμό της Παγκόσμιας Ημέρας κατά του Καπνίσματος, διοργάνωσε ενημερωτική εκδήλωση, με θέμα «Η υγεία των πνευμόνων για τη μακροζωία και την ευεξία. Τρίκαλα, η πρώτη πόλη ελεύθερη καπνού», με την ευγενική χορηγία της φαρμακευτικής εταιρείας Pfizer Hellas. Σκοπός της εκδήλωσης ήταν, αφενός, η ενημέρωση του …
Περισσότερα »Διαχρονικές ευθύνες καταλογίζει ο ΙΣΑ στο Υπουργείο για απώλειες ασθενών από ενδονοσοκομειακές λοιμώξεις
Ο Ιατρικός Σύλλογος Αθηνών καταγγέλλει με ανακοίνωσή του τις σοβαρές ευθύνες της πολιτικής ηγεσίας του Υπουργείου Υγείας για την ακύρωση δωρεάς του Ιδρύματος Σταύρος Νιάρχος, σχετικά με πρόγραμμα που αφορά την εκπαιδευτική δράση για την αντιμετώπιση των ενδονοσοκομειακών λοιμώξεων. «Η επιστημονική κοινότητα εδώ και χρόνια, κρούει τον κώδωνα του κινδύνου, καθώς η χώρα μας έχει ιδιαίτερα αυξημένα ποσοστά ενδονοσοκομειακών λοιμώξεων …
Περισσότερα »Πλήγμα από το ΙΣΝ: Ακύρωση δωρεάς προς το Ελληνικό Δημόσιο για τις ενδονοσοκομειακές λοιμώξεις
Σε ακύρωση προγραμματισμένης δωρεάς στο Υπουργείο Υγείας σχετικά με την εκπαιδευτική δράση για τις ενδονοσοκομειακές λοιμώξεις προχώρησε το Ίδρυμα Σταύρος Νιάρχος (ΙΣΝ), όπως ανακοινώθηκε και στην 4η τακτική τριμηνιαία ενημέρωση για την πρόοδο των εργασιών του Μνημονίου Συνεργασίας μεταξύ Ελληνικού Δημοσίου και ΙΣΝ: «Σε ό,τι αφορά τη δεύτερη εκπαιδευτική δράση της Πρωτοβουλίας, το Ίδρυμα Σταύρος Νιάρχος είχε προτείνει στο Υπουργείο Υγείας …
Περισσότερα »5 Μαΐου: Παγκόσμια Ημέρα για την Υγιεινή των Χεριών
Σύμφωνα με τα δεδομένα του Παγκόσμιου Οργανισμού Υγείας, 1 στους 10 ασθενείς μπορεί να εμφανίσει λοίμωξη που συνδέεται με τη νοσηλεία του, ενώ ειδικότερα οι λοιμώξεις χειρουργικού πεδίου, σε ποσοστό μεγαλύτερο του 50%, προκαλούνται από ανθεκτικά μικρόβια. Η πρόληψη των λοιμώξεων σώζει καθημερινά εκατομμύρια ανθρώπινες ζωές. Η Υγιεινή των Χεριών (ΥΧ) αναφέρεται στην παροχή ιατρονοσηλευτικής φροντίδας με καθαρά χέρια, ώστε …
Περισσότερα »14ο Παγκρήτιο Φαρμακευτικό Συνέδριο: Το φαρμακείο αλλάζει, αλλά “ζει”
Το Παγκρήτιο Φαρμακευτικό Συνέδριο είναι ο πρώτος ιστορικά συνεδριακός φαρμακευτικός θεσμός, με λαμπρή ιστορία και παράδοση επιτυχίας. Απευθύνεται σε όλους τους φαρμακοποιούς της Ελλάδας και συγκεντρώνει πάντα το ενδιαφέρον του συνόλου των φαρμακοποιών της Κρήτης, αλλά και εκατοντάδων φαρμακοποιών από άλλα μέρη της χώρας. To 14o Παγκρήτιο Φαρμακευτικό Συνέδριο, το οποίο διοργανώνεται από το Συντονιστικό Όργανο Φαρμακευτικών Συλλόγων Κρήτης, με …
Περισσότερα »Υποστελέχωση ΓΝ Σύρου: Κρούουν τον κώδωνα του κινδύνου οι εργαζόμενοι
Όπως σημειώνουν σε ανακοίνωσή τους οι εργαζόμενοι στο Νοσοκομείο Σύρου, παρόλο που τα τελευταία χρόνια γίνονται προσπάθειες ανάπτυξης του Νοσοκομείου (πτητική βάση ΕΚΑΒ, εγκατάσταση σύγχρονου ιατροτεχνολογικού εξοπλισμού, λειτουργία παιδιατρικής κλινικής και προετοιμασία για έναρξη ΜΑΦ κ.λπ.), όλα «ακυρώνονται» σε μεγάλο βαθμό από τη σοβαρή υποστελέχωση από μόνιμο προσωπικό στη Νοσηλευτική, Τεχνική και Διοικητική Υπηρεσία. Χαρακτηριστικά, από τη Νοσηλευτική Υπηρεσία έχουν …
Περισσότερα »Η θεατρική ομάδα “panDEMOnium” της DEMO ABEE στην Ογκολογική Μονάδα Παίδων
Η ομάδα “panDEMOnium” της DEMO ABEE συνεργάστηκε με τη Δράση Δημιουργικής Απασχόλησης του Οργανισμού «Το Χαμόγελο του Παιδιού», η οποία βρίσκεται καθημερινώς στα νοσοκομεία παίδων, για να απασχολεί με παιχνίδι και ψυχαγωγικές δραστηριότητες τους μικρούς ασθενείς. Η θεατρική ομάδα των εργαζομένων της DEMO, με σκηνικά και κουστούμια, έπαιξε σκηνές από το θεατρικό έργο «Οδυσσεβάχ» της Ξένιας Καλογεροπούλου, ενώ στο τέλος …
Περισσότερα »Αίτηση ακύρωσης της υπουργικής απόφασης στο ΣτΕ κατέθεσε ο ΠΙΣ
Αίτηση ακύρωσης της υπουργικής απόφασης με την οποία δεν επικυρώνονται τα αποτελέσματα των τελευταίων εκλογών του Πανελλήνιου Ιατρικού Συλλόγου (ΠΙΣ), κατέθεσε το εκλεγμένο ΔΣ του ΠΙΣ στο Συμβούλιο της Επικρατείας (ΣτΕ). Το πρωί της Πέμπτης, 2 Μαΐου, τα εκλεγμένα μέλη του ΔΣ του ΠΙΣ προχώρησαν στην κατάθεση του αιτήματος ακύρωσης της Υπουργικής Απόφασης, με την οποία ο Υπουργός Υγείας, επικαλούμενος …
Περισσότερα » Health Update Health Update
Health Update Health Update